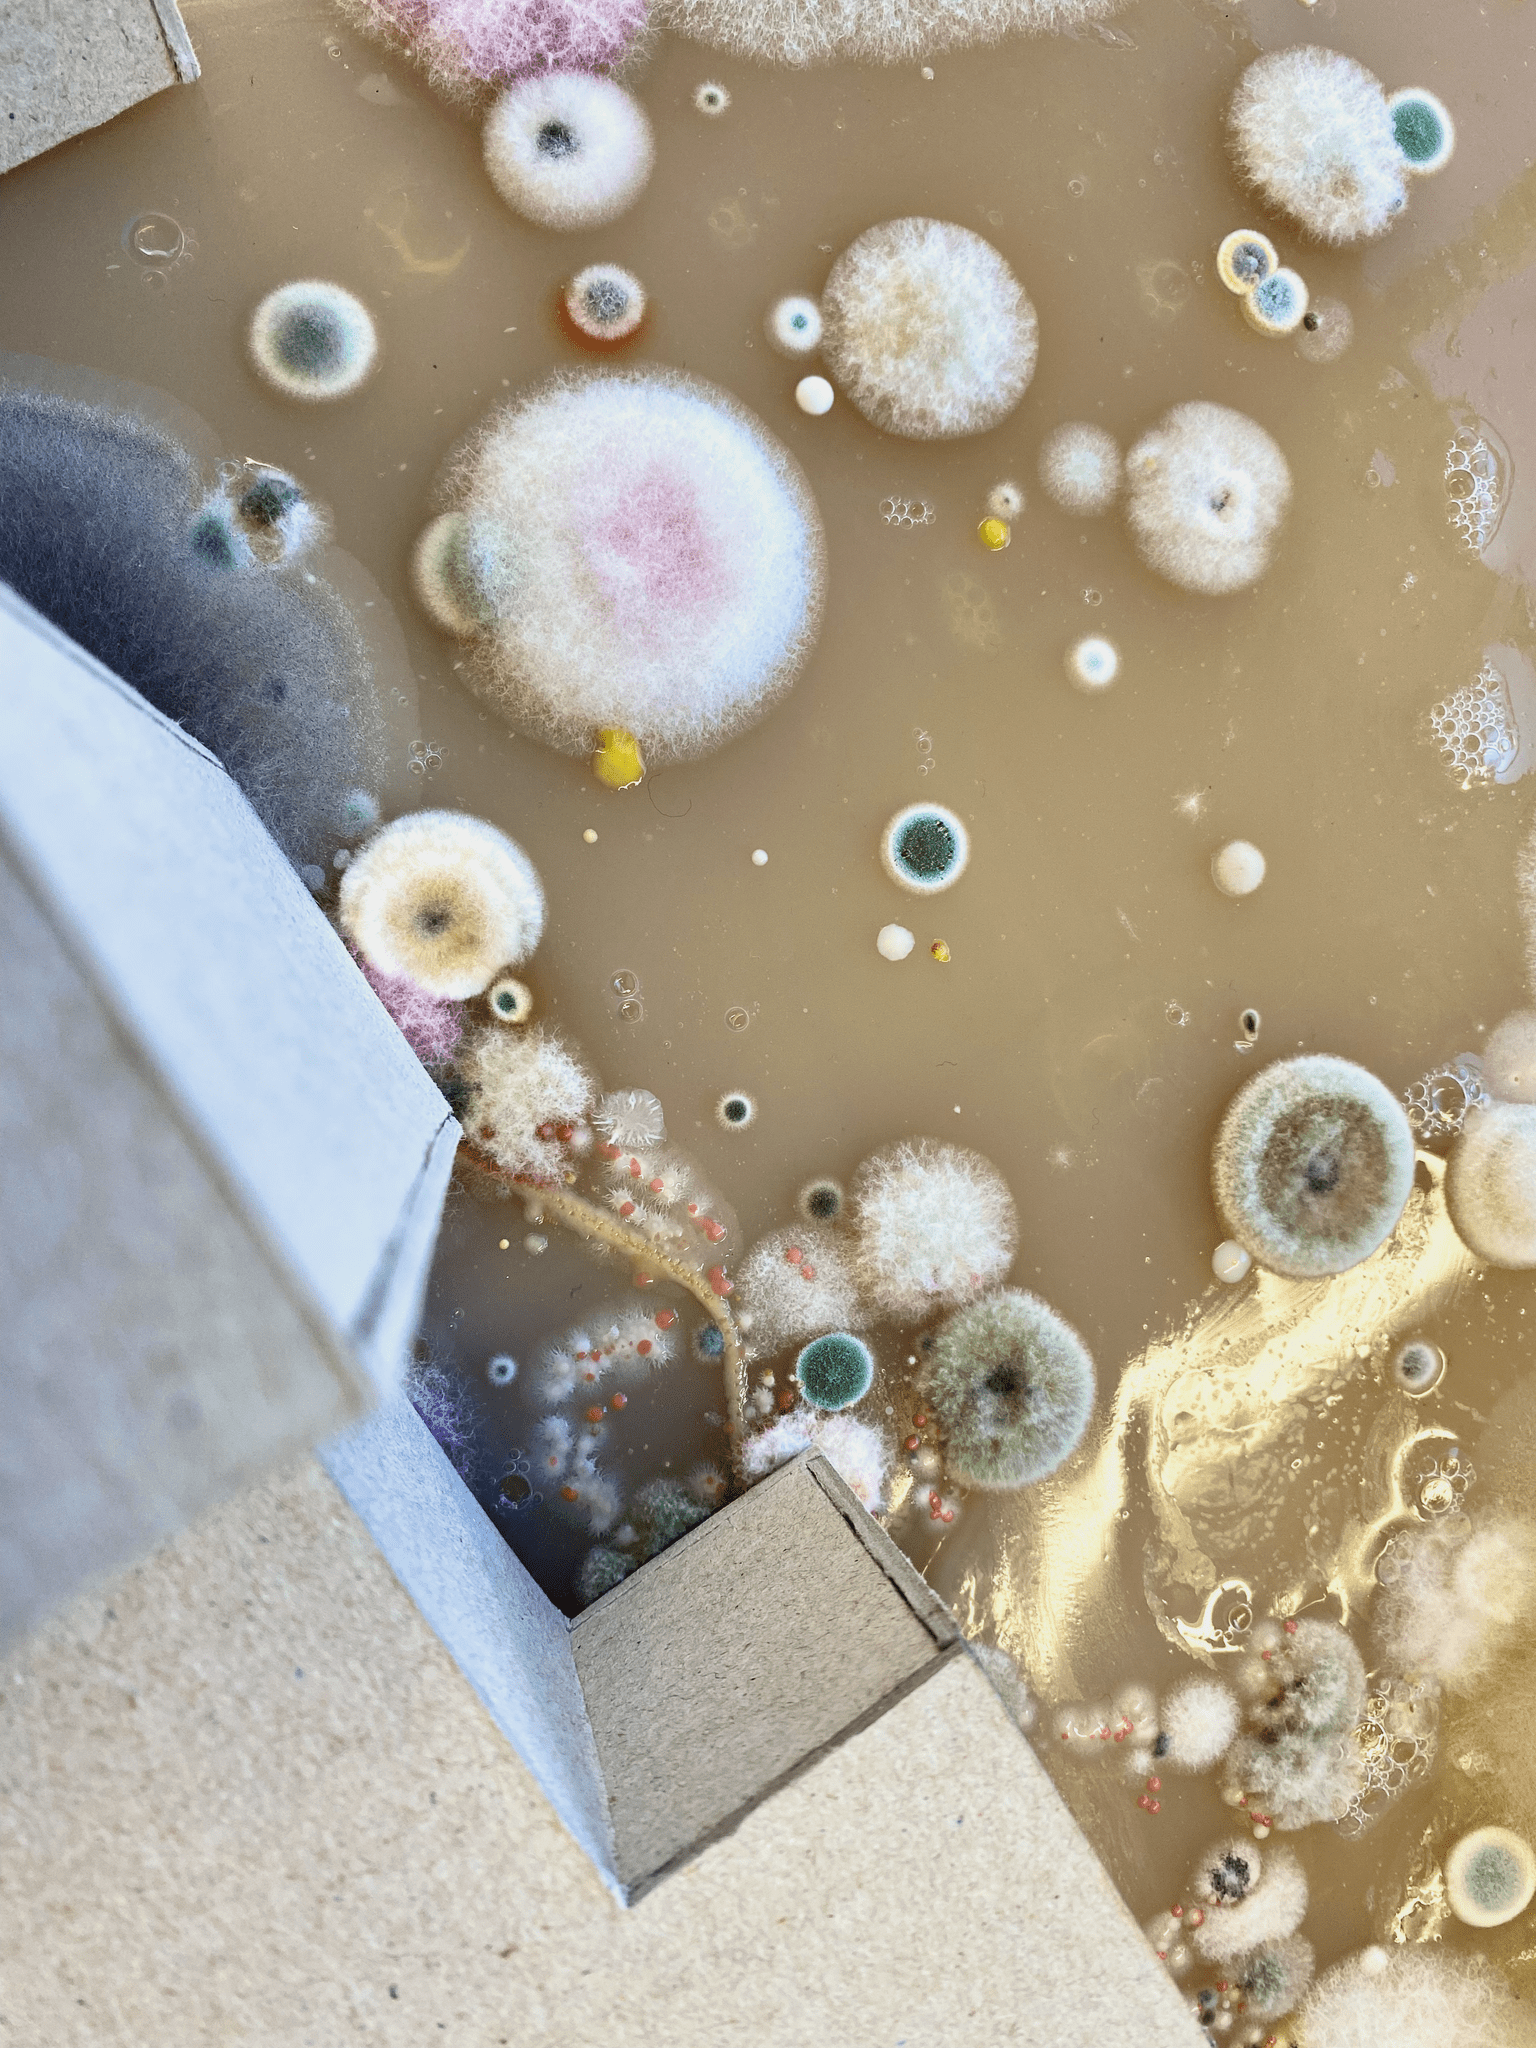
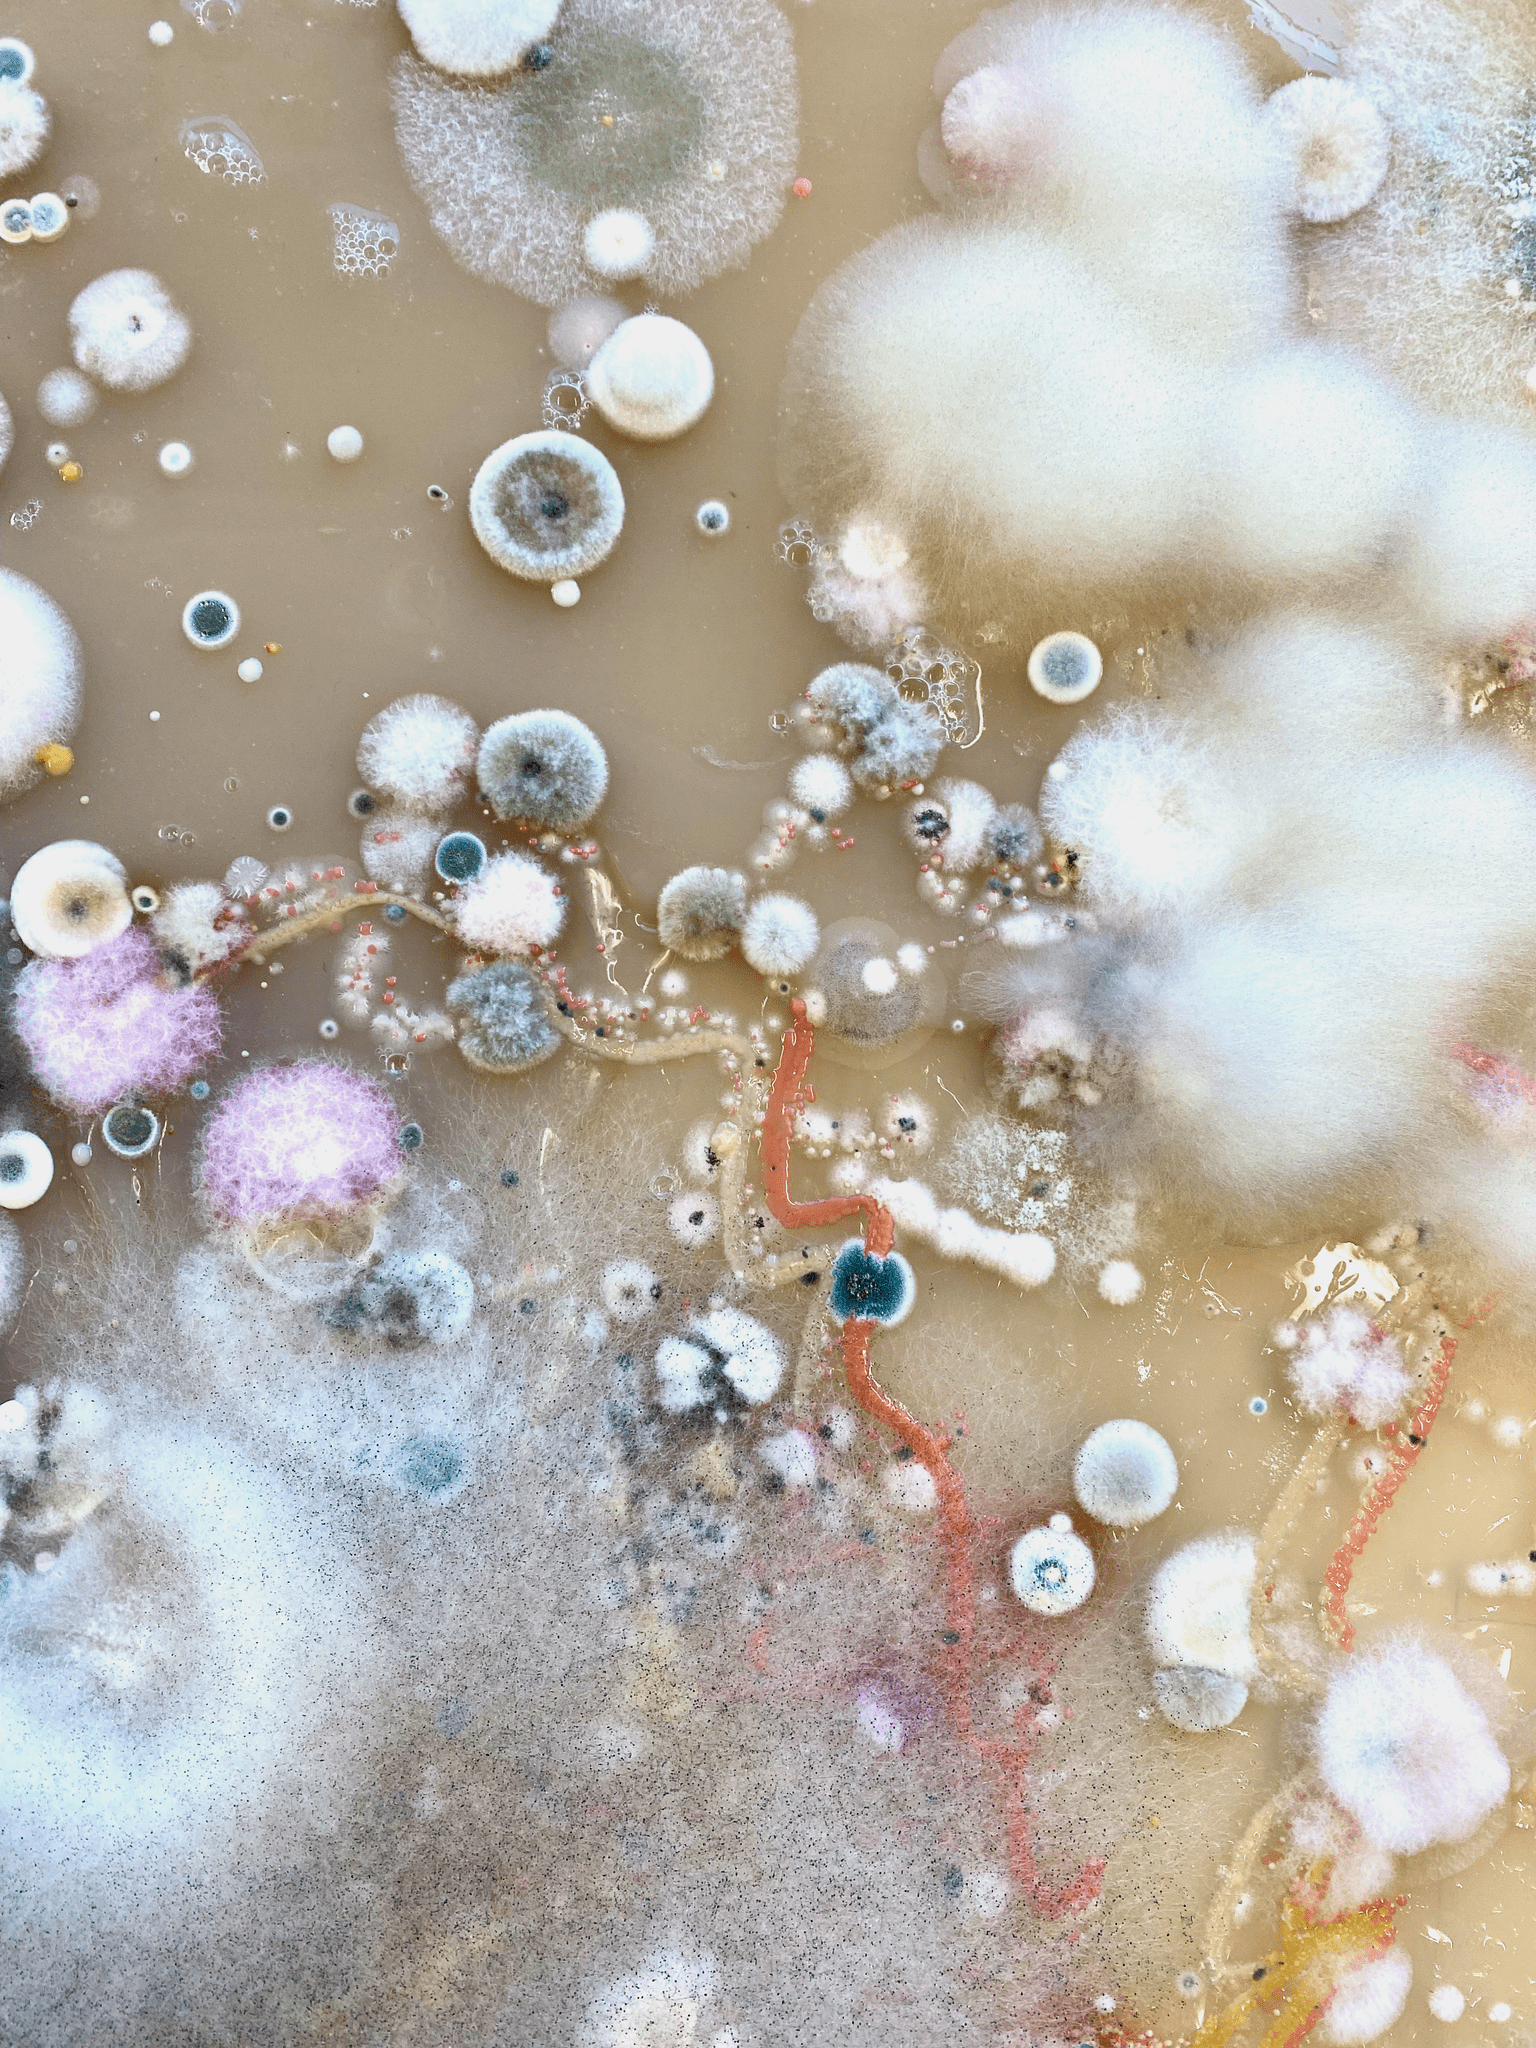
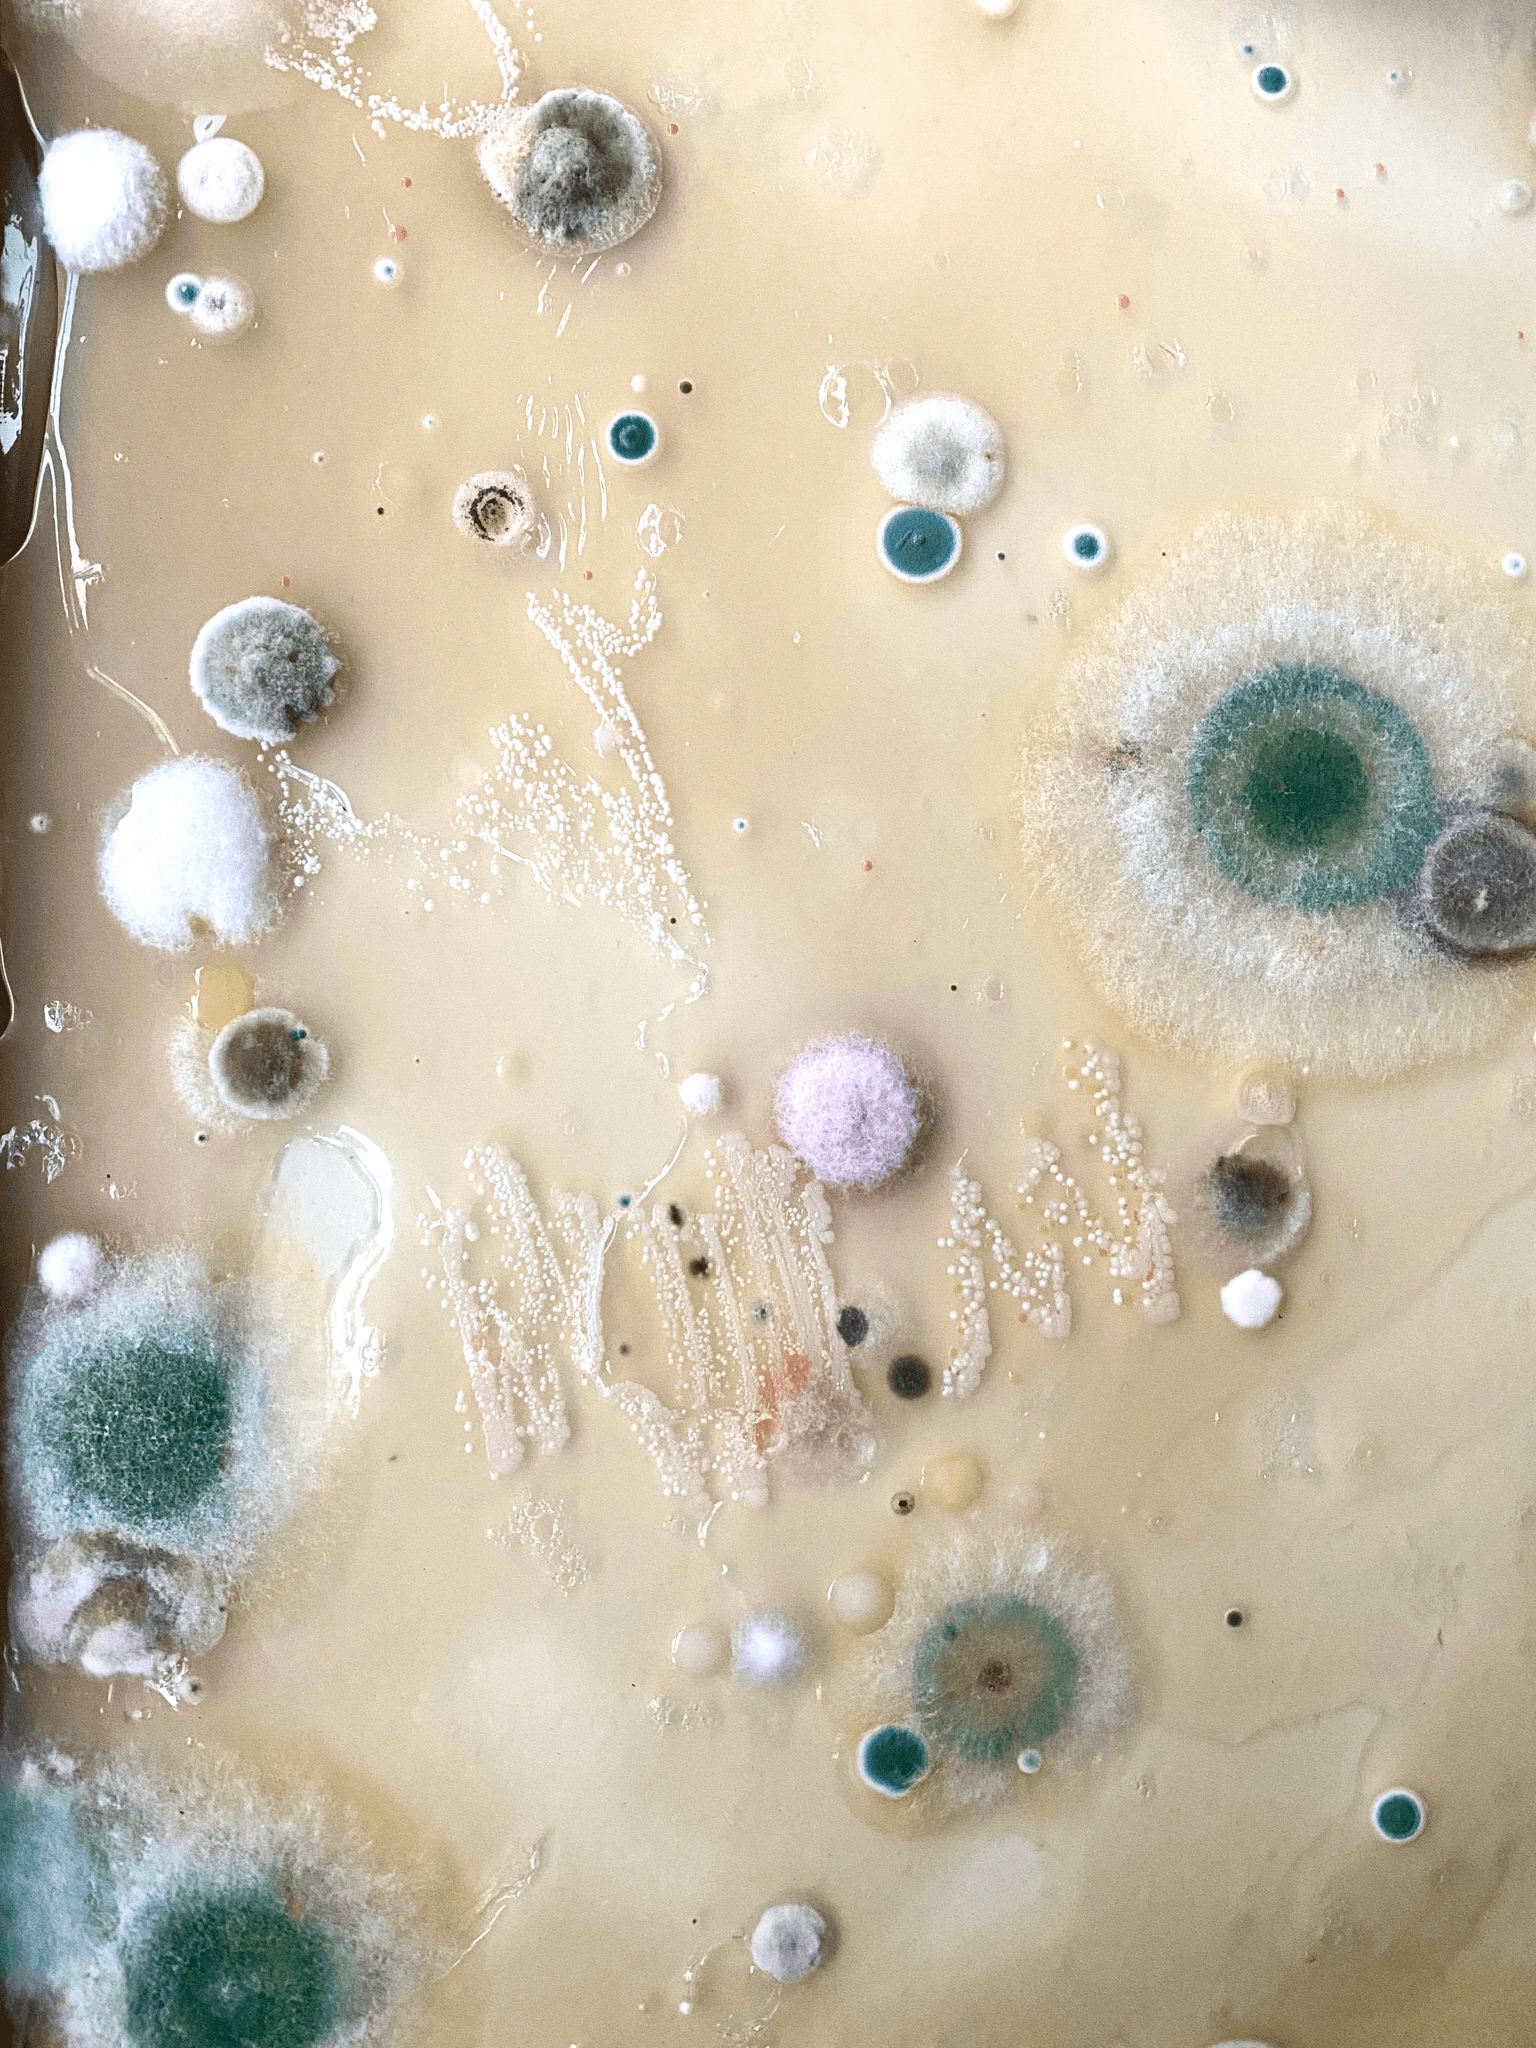

Planeta Kampus originated from a collective frustration among Master's degree students of Environmental Design for Architecture regarding the discourse surrounding climate change. The project aims to confront the imperative to move away from the anthropocentric narrative deeply embedded in various aspects of Western life, identified as a primary driver of accelerating global warming.
The project has two poles – a fictional story taking place on the campus of the University of West Bohemia, in which nature has intensified its processes and is spreading beyond its borders, which is presented through text and a computer game, and environmental creation itself, in which the team of authors collaborates with mold in designing 3D artifacts and from which the physical model and 3D generated objects were created.
The original assignment was to propose environmental interventions on the campus of the University of West Bohemia in Pilsen that could take an ordinary urban space and create from it an environment that would be friendlier to users and nature. The basic features of the project were outlined during October 2021. The team of Planeta Kampus authors consists of people from various studios of the Ladislav Sutnar Faculty of Design and Art – from the areas of the audiovisual arts, design or graphics, who chose the studio of environmental design as their second specialization within the framework of their master’s studies.
They are all united by an interest in environmental topics and conceptualize a multispecies ecology in their projects. Together, they created a model of the campus, which they inoculated with various impurities that they took directly from the university buildings. Then they let these organisms grow and filmed the entire project. RGB data was collected from the video, which was then converted to curves and transferred to XYZ coordinates, from which spatial objects in the form of metaballs were generated, subsequently creating various objects. It is an organic architecture that is generated by nature itself, completely uncontrolled by the human will.
In environmental design, the question of the action of other, non-human organisms is often raised. The use of mold seemed highly suitable, as it is an organism that is one of the least popular in human households, and at the same time it harbors incredible strength and vitality and now plays a major role in the generation of objects. Planeta Kampus is influenced by frustration with the discourse surrounding the deteriorating climate. The goal of the project is to draw attention to the anthropocentric narrative, which is identified as the main cause of accelerating global warming.
The main axis of the project is the use of ubiquitous organisms and their growth to imagine alternative worlds. Planeta Kampus is both ecological imagination and imaginative ecology. It takes place in fictitious time-spaces, in a dream world where massive tree roots overgrown with multicolored lichens communicate with microscopic organisms through extensive mycelial networks. It is an alternative world that carries a message to transform our thinking, imagination and our behavior and relationship with the world.
It is an inspiration for new possible attitudes towards the Earth and direct relationships with it. Every living creature belongs here in principle.
It is the message to transform our thinking, imagination and our behavior and relationship with the world. It is an inspiration for new possible attitudes towards the Earth and direct relationships with it. Every living creature belongs here in principle.